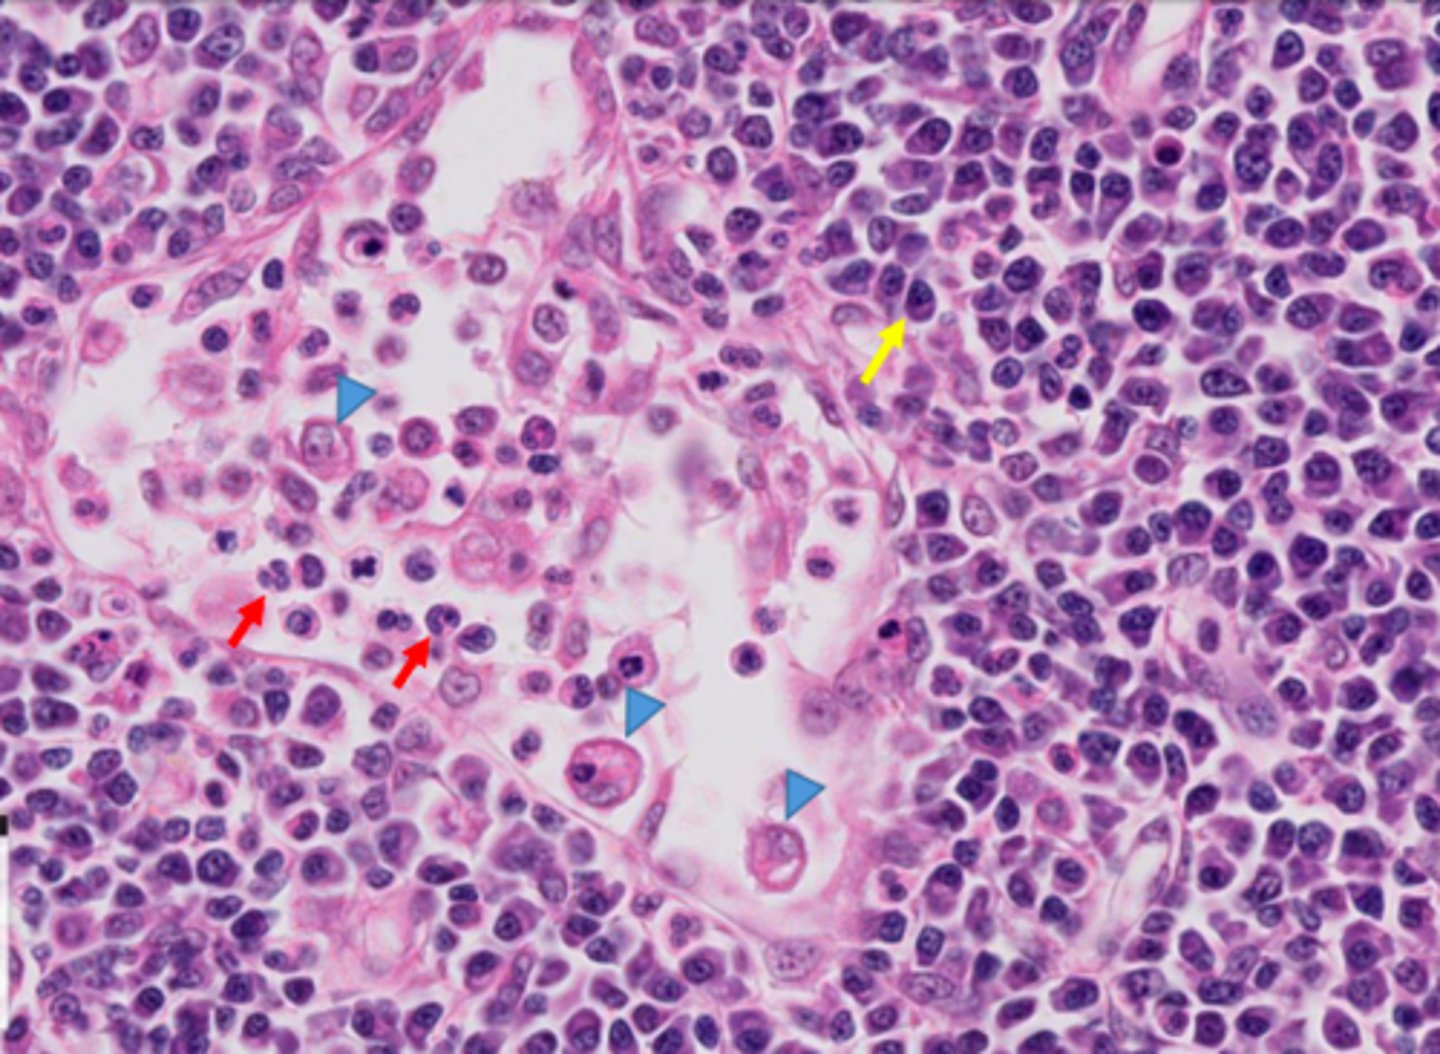

Lymph Node Cytology
1/19
There's no tags or description
Looks like no tags are added yet.
Name | Mastery | Learn | Test | Matching | Spaced |
|---|
No study sessions yet.
20 Terms
Reasons why a lymph node can be enlarged?
Abundant fat in capsule (due to BCS or age), a reactive lymph node where lymphocyte within have met their specific antigen, a lymphadentitic lymph node (infiltration of inflammatory cells either due to draining an area of inflammation or of the node itself), or a neoplasticism lymph node (increase in immature large lymphocytes)
Small lymphocytes in lymph node

Large lymphocytes in lymph node

Plasma cell in lymph node - yellow arrow

Macrophage in lymph node - blue arrows
What criteria will you use to determine the size of lymphocytes?
Size of neutrophils?
What would a normal lymph node cytology sample consist of?
Composed mostly of small lymphocytes (80-90%), low numbers of immature lymphocytes, and low numbers of other cells such as macrophages, neutrophils, plasma cells, etc
Which lymph node might you sample if a mass/lesion is found on the manus, antebrachium, or lateral brachium, neck or back of head?
Superficial cervical lymph node
Which lymph node might you sample if a mass/lesion is found on the pes or crus?
Popliteal lymph node.
Which lymph node might be swollen if a mass or lesion is on the medial aspect of the brachium, a deep structure of the thoracic wall, thoracic mammary and cranial abdominal mammal?
Axillary lymph node
How could you tell if you took a sample of salivary gland, rather than the mandibular lymph nodes
Upon cytology, salivary gland cells will clump together like epithelium, while lymph node cells would not do this. You should also expect to see lymphocytes in lymph node tissue, but not in the salivary gland
Plasma cells

Trabecula of Lymph node
(indicated by blue arrow)

Subcapsular sinus of lymph node
(indicated by red arrows)

Trabecular Sinus of lymph node
(indicated by green arrows)

Lymphatic Nodules (follicles)

Capsule of Lymph node
indicated by yellow arrow

medullary sinuses of lymph node
indicated by red arrows

Medullary cords of lymph node
indicated by blue arrows

consider buying Sarah a coffee :)
your contribution is much appreciate and supports a resident during their boards studying
